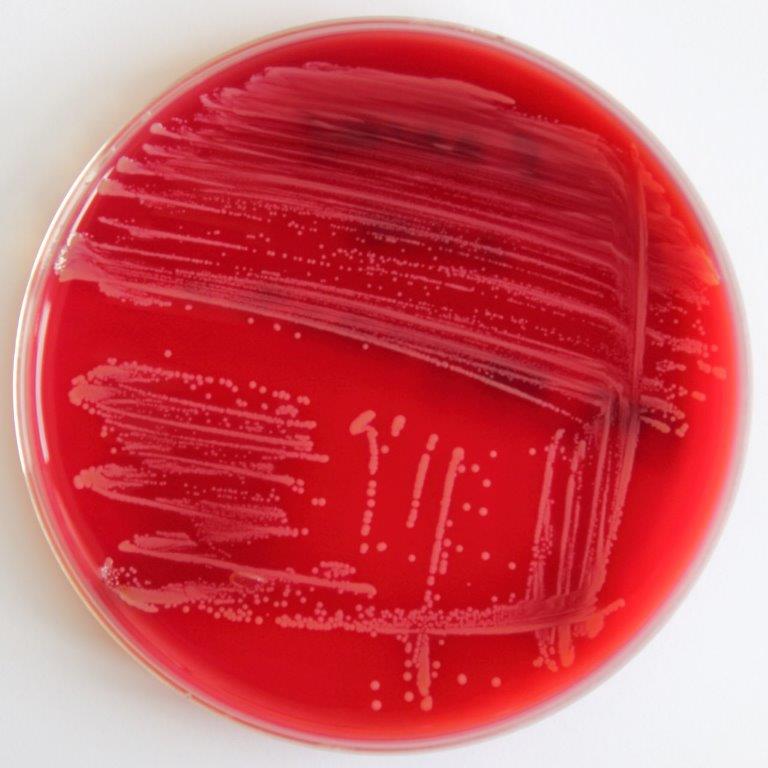

Willkommen
Willkommen auf der Webseite von ”Make udder health happen (MUHH)”! Auf dieser Seite können Sie vielfältige Informationen zur Verbesserung der Eutergesundheit Ihrer Milchkühe oder zur modernen gezielten Therapie von Euterentzündungen finden. Die Inhalte dieser Seite sind Ergebnisse unserer Forschungsarbeit und werden nach und nach erweitert. So können Sie hier einseitige Erläuterungen – sogenannte Factsheets – aber auch unsere wissenschaftlichen Artikel finden, soweit sie unter Open Access Lizenzen veröffentlicht werden. Sie können die Inhalte gern herunterladen und verwenden, solange Sie uns dabei zitieren.
Die Webseite „Make udder health happen“ wird von der Arbeitsgruppe Mikrobiologie der Hochschule Hannover und dem Steinbeis Research Center Milk Science gestaltet. Sie können uns unter info@muhh.eu
erreichen.
Welcome
Welcome to the website of "Make udder health happen (MUHH)"! On this site, you can find various information about how to improve the udder health of your dairy cows or about modern targeted therapy of udder inflammations. The contents of this site are the results of our research work and will be extended gradually. You can find one-page explanations - so-called fact sheets (unfortunately in German) - but also our scientific articles, as far as they are published under Open Access licenses. You are welcome to download and use the contents as long as you quote us.
The website "Make udder health happen" is designed by the Microbiology Group of the Hannover University of Applied Sciences and the Steinbeis Research Center Milk Science. You can reach us at info@muhh.eu.